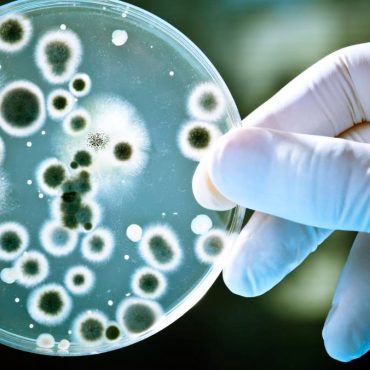

BTS officially kicked off its offline event 2025 BTS FESTA on Friday (June 13) at Halls 9 and 10 of KINTEX Exhibition Center 2 in Goyang, Gyeonggi Province, in celebration of the group’s 12th debut anniversary. Running for two days from June 13 to 14, this year’s FESTA features a variety of hands-on experiences designed especially for their fandom, ARMY.
The theme for this year’s FESTA is Twelve O’Clock, symbolizing the beginning of a new chapter and hinting at the group’s imminent full-group return. BTS members Jin and j-hope introduced the concept in the YouTube segment BTS News released in early June, marking their first official appearance in a while.
The event is open from 10 a.m. to 7 p.m KST, with last entry allowed until 6 p.m. Admission is available for fans age 9 and above; children under 9 are not permitted to enter, regardless of parental accompaniment.
From early in the morning, countless fans holding ARMY Bomb light sticks gathered at the venue, filling the KINTEX exhibition halls. Long lines quickly formed in front of the most popular interactive zones.
The venue includes more than 20 interactive zones. Below, we have a closer look at a few of the zones.
1. ARMY BOMB PHOTO SPOT & WHALE PHOTO SPOT
Two large-scale installations greet fans as they enter: the ARMY BOMB PHOTO SPOT and the WHALE PHOTO SPOT, both inspired by BTS’ signature motifs.
2. LIGHT SHOW
Beginning at noon, a five-minute light show takes place every hour on the hour, utilizing the synchronized ARMY Bomb light sticks to create a breathtaking visual spectacle. Widely praised by fans and media alike, the light show transformed the venue into an emotionally charged atmosphere and was hailed as one of the major highlights of the event.
3. VOICE ZONE
The Voice Zone offers an emotional connection as fans listen to voice messages recorded by BTS members specifically for the 2025 FESTA. These messages carry deeper meaning as the members participated directly in scripting them.
4. BTS LOCKER
BTS Locker presents personalized displays curated by each member, offering a look into their tastes, personalities, and memories.
5. TROPHY ZONE
The Trophy Zone commemorates BTS’s historic milestones. The display includes 50 trophies, from their first rookie award at the 5th Melon Music Awards in 2013 to their first music show win on KBS2’s Music Bank in 2015, and their first international honor at the Billboard Music Awards in 2017. Awards received by ARMY, such as the iHeartRadio Music Awards’ “Best Fan Army,” are also on display, reflecting the shared journey of the group and its fans.
6. COLORING WALL
The Coloring Wall, where fans filled in a large white artwork outline, was a participatory art zone at the 2025 BTS FESTA. Fans added their own colors and personal touches to the mural, contributing to its creation while covering the wall with heartfelt messages of support for BTS.
With an array of immersive experiences and engaging attractions tailored for fans, the 2025 BTS FESTA proved to be more than just a celebration — it was a heartfelt tribute to BTS’s legacy and their long-awaited return as a full group.
BIGHIT MUSIC stated, “We are sincerely grateful to ARMY for the unwavering love and support for BTS,” adding, “To better accommodate visitors, we have significantly expanded the event in terms of venue, content, and operations compared to previous years. We are doing our utmost to ensure that all attendees can enjoy a safe and meaningful experience.”
See photos of all the interactive zones below:

Post comments (0)